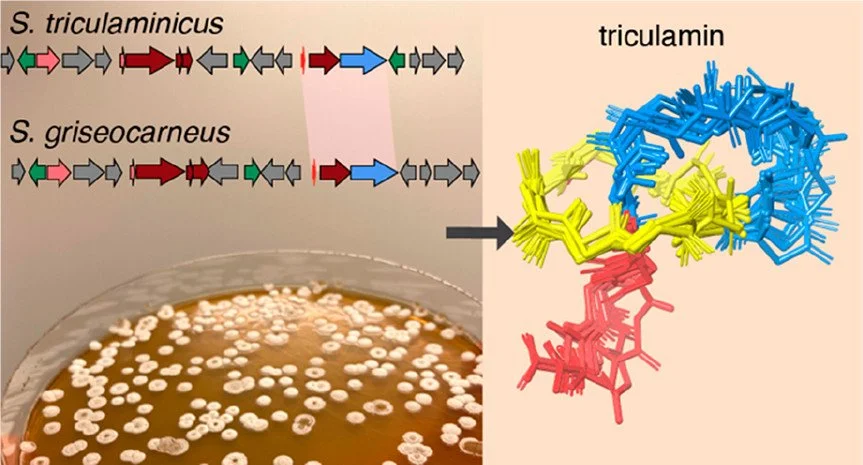
57. F. D. Andersen, K. D. Pedersen, D. Wilkens Juhl, T. Mygind, P. Chopin, E. B. Svenningsen, T. B. Poulsen, M. Braad Lund, A. Schramm, C. H. Gotfredsen, T. Tørring, "Triculamin: An Unusual Lasso Peptide with Potent Antimycobacterial Activity",  J.

Publications from the Thomas Poulsen lab
Click the graphical abstract to read the article.
Preprints
E. B. Svenningsen, F. Demir, F. E. H. Kromm, A. H. F. Rahimic, D. Olagnier, M. M. Rinschen, T. B. Poulsen, “Chemoproteomic mapping of the N-terminal cysteinome”, ChemRxiv, 2024, DOI: 10.26434/chemrxiv-2024-4w549
Peer-reviewed publications
81. M. R. S. Nielsen, S. Beyerstedt, H. Zhao, A. E. Kiib, T. B. Poulsen, M. A. Ramos Docampo, “On the synthesis of chiral gold nanorods”, Nanoscale, 2026, DOI: 10.1039/D6NR00823B
First seen on ChemRxiv: doi.org/10.26434/chemrxiv-2025-x82rx
80. B. B. Andersen, S. Kemble, S. Greisen, J. Thyrsted, V. R. Schack, E. Fuchs, A. L. Hansen, T. B. Poulsen, C. K. Holm, D. Olagnier, A. Croft, B. Deleuran, M. A. Nielsen, “4-Octyl itaconate inhibits synovial fibroblast activation by targeting Nrf2 to exert anti-inflammatory effects in rheumatoid arthritis”, EULAR Rheumatol. Open., 2026, 100190, DOI: 10.1016/j.ero.2026.100190
79. T. Bergonci, T. K. Rosenbæk, S. J. Windross, U. B. Keiding, E. Pinilla, K. P. Stuckert, J. Hansen, C. B. Nielsen, J. P. Gomes, L. R. Davies, J. Palmfeldt, V. Loeschcke, C. U. Andersen, U. Simonsen, T. B. Poulsen, M. Johannsen, “Dual pharmacological targeting of coactivator-associated arginine methyltransferase 1 (CARM1) and salt inducible kinase (SIK) drives ketogenesis in both hepatocytes and mice”, Br. J. Pharmacol., 2026, 1–17, DOI: 10.1111/bph.70447
78. K. X. Ali, D. Klenja-Skudrinja, M. Higgins, D. Walker, Y. Sharaf, M. Dankis, A. A. H. Patel, D. Raj, J. J. Dzanan, E. B. Svenningsen, A. Langlands, T. Poulsen, T. Honda, A. T. Dinkova-Kostova, C. Wiel, V. I. Sayin, L. de la Vega, “Development of a high-throughput screening platform for identification of functional BACH1 inhibitors reveals compounds with anti-invasive potential”, Redox Biol., 2026, 94, 104187, DOI: 10.1016/j.redox.2026.104187
77. S. L. B. Møller, T. B. Poulsen, “Construction of C(sp3)–C(sp3) attached ring motifs in natural product synthesis”, Nat. Prod. Rep., 2026, DOI: 10.1039/D6NP00024J
76. M. S. Tvilum, C. B. Nielsen, I. Steensgaard, T. B. Poulsen, M. Johannsen, T. Tørring, “Hypoxia-induced production of the cyclolipodepsipeptide BE-43547 by Micromonospora sp. RV43”, Microbiology, 2026, 172:001662, DOI: 10.1099/mic.0.001662
75. F. E. H. Kromm*, S. L. B. Møller*, A. S. Jensen, G. J. Wørmer, M. H. Rasmussen, E. B. Svenningsen, T. Tørring, T. B. Poulsen, “Modular Total Synthesis of Lasalocid Acid A through Direct C(sp3)–C(sp3) Attached Ring Construction”, J. Am. Chem. Soc., 2026, 148, 249-257, DOI: 10.1021/jacs.5c11543
*These authors contributed equally
Highlighted in Synfacts: doi.org/10.1055/a-2806-6450
First seen on ChemRxiv: doi.org/10.26434/chemrxiv-2025-4r44q
74. F. Demir, E. Kovalenko, M. Lassé, E. B. Svenningsen, J. M. B. Jensen, A. M. Billing, K. Groeneveld, A. Hutzfeldt, L. Nilges, J. P. L. Guerra, K. J. Pietrzak-Lichwa, Y. Tan, E. Colby, A. G. Hansen, N. Kurmasheva, D. Olagnier, D. Choi, M. M. Richter, S. D. Laufer, F. Braun, S. A. Johnson, M. Krüger, T. B. Huber, E. Hoxha, O. M. Steinmetz, R. Mrowka, S. Melderis, M. A. Saleem, T. B. Poulsen, G. R. Andersen, S. Thiel, A. Troldborg, M. M. Rinschen, “Proteolytic profiling of human plasma reveals an immunoactive complement C3 fragment”, EMBO J., 2025, 44, 7721-7758, DOI: 10.1038/s44318-025-00598-8
73. D. Diprima*, T. T. Paulsen*, A. Pulcinella*, S. Bonciolini, A. L. Gabbey, R. Stuhr, T. B. Poulsen, T. Noël, “Modular Synthesis of Substituted Lactams via a Deoxygenative Photochemical Alkylation–Cyclization Cascade of Secondary Amides in Flow”, JACS Au, 2025, 5, 4584-4592, DOI: 10.1021/jacsau.5c00884
*These authors contributed equally
Highlighted in Synfacts: doi.org/10.1055/a-2783-0105
First seen on ChemRxiv: doi.org/10.26434/chemrxiv-2025-6qf93
72. M. H. Rasmussen, S. L. B. Møller, E. B. Svenningsen, T. Tørring, T. B. Poulsen, “P450 Enzyme LyoI Performs Hydro-2,2′-Bifuran Oxidation in the Polyether Ionophore Lysocellin”, Angew. Chem. Int. Ed., 2025, 64, e202507847, DOI: 10.1002/anie.202507847
First seen on ChemRxiv: doi.org/10.26434/chemrxiv-2025-bdxkm
71. Y. Zhang, G. Renno, G. J. Wørmer, A. M. Tamr, O. Thorn-Seshold, T. B. Poulsen, N. Sakai, S. Matile, “Reversible Conjugate Addition in Thiol-Mediated Uptake”, Helv. Chim. Acta, 2025, 108, e00091, DOI: 10.1002/hlca.202500091
70. M. D. Opfermann, M. B. Søndergård, L. V. Bech, C. B. Nielsen, A. Mahía, C. B. Holt , T. Wang, S. B. Olesen, K. Frisch, J. A. Østergaard, D. Britz, K. L. Nielsen, J. J. Galligan, T. B. Poulsen, J. Hansen, M. Johannsen, “Reactivity-based metabolomics reveal cysteine has glyoxalase 1-like and glyoxalase 2-like activities”, Nat. Chem. Biol., 2025, 21, 1397-1407, DOI: 10.1038/s41589-025-01909-0
69. T. T. Paulsen*, A. E. Kiib*, G. J. Wørmer, S. M. Hacker, T. B. Poulsen, “Total syntheses of cyclohelminthol I–IV reveal a new cysteine-selective covalent reactive group”, Chem. Sci., 2025, 16, 3916-3927, DOI: 10.1039/d4sc08667h
*These authors contributed equally
68. R. N. Ottosen, J. M. Seefeldt, J. Hansen, R. Nielsen, N. Møller, M. Johannsen, T. B. Poulsen, “Preparation and Preclinical Characterization of a Simple Ester for Dual Exogenous Supply of Lactate and Beta-hydroxybutyrate”, J. Agric. Food Chem., 2024, 72, 19883–19890, DOI: 10.1021/acs.jafc.4c04849
67. N. Kurmasheva, A. Said, B. Wong, P. Kinderman, X. Han, A. H. F. Rahimic, A. Kress, M. E. Carter-Timofte, E. Holm, D. van der Horst, C. F. Kollmann, Z. Liu, C. Wang, H.-D. Hoang, E. Kovalenko, M. Chrysopoulou, K. S. Twayana, R. N. Ottosen, E. B. Svenningsen, F. Begnini, A. E. Kiib, F. E. H. Kromm, H. J. Weiss, D. Di Carlo, M. Muscolini, M. Higgins, M. van der Heijden, A. Bardoul, T. Tong, A. Ozsvar, W.-H. Hou, V. R. Schack, C. K. Holm, Y. Zheng, M. Ruzek, J. Kalucka, L. de la Vega, W. A. M. Elgaher, A. R. Korshoej, R. Lin, J. Hiscott, T. B. Poulsen, L. A. O’Neill, D. G. Roy, M. M. Rinschen, N. van Montfoort, J.-S. Diallo, H. F. Farin, T. Alain, D. Olagnier, "Octyl itaconate enhances VSVΔ51 oncolytic virotherapy by multitarget inhibition of antiviral and inflammatory pathways", Nat. Commun., 2024, 15, 4096, DOI: 10.1038/s41467-024-48422-x
66. P. Waser, J. Faghtmann, M. Gil-Ordóñez, A. Kristensen, E. B. Svenningsen, T. B. Poulsen, K. A. Jørgensen, “Enantioselective Synthesis of α-Quaternary Isochromanes by Oxidative Aminocatalysis and Gold Catalysis”, Chem. Eur. J., 2024, 30, e202401354, DOI: 10.1002/chem.202401354
65. J. Faghtmann, M. Eugui, J. N. Lamhauge, S. S. P. Andresen, A. R. Østergaard, E. B. Svenningsen, T. B. Poulsen, K. A. Jørgensen, “An Enantioselective Aminocatalytic Cascade Reaction Affording Bioactive Hexahydroazulene Scaffolds”, Chem. Eur. J., 2024, 30, e202401156, DOI: 10.1002/chem.202401156
64. S. L. B. Møller, M. H. Rasmussen, J. Li, E. B. Svenningsen, G. J. Wørmer, T. Tørring, T. B. Poulsen, “The Biological Activities of Polyether Ionophore Antibiotic Routiennocin is Independent of Absolute Stereochemistry”, ChemBioChem, 2024, 25, e202400013, DOI: 10.1002/cbic.202400013
63. M. Busk, P. P. Eggertsen, J. Overgaard, M. R. Horsman, T. Tørring, K. M. Jacobsen, T. B. Poulsen, “In Vitro Characterization of the Bacteria-derived Hypoxia-selective Cytotoxin BE-43547”, Anticancer Res., 2023, 43, 5319-5329, DOI: 10.21873/anticanres.16735
62. F. H. Waqas, M. Shehata, W. A. M. Elgaher, A. Lacour, N. Kurmasheva, F. Begnini, A. E. Kiib, J. Dahlmann, C. Chen, A. Pavlou, T. B. Poulsen, S. Merkert, U. Martin, R. Olmer, D. Olagnier, A. K. H. Hirsch, S. Pleschka, F. Pessler, “NRF2 activators inhibit influenza A virus replication by interfering with nucleo-cytoplasmic export of viral RNPs in an NRF2-independent manner”, PLOS Pathog., 2023, 19, e1011506, DOI: 10.1371/journal.ppat.1011506
61. M. Wollesen, K. Mikkelsen, M. S. Tvilum, M. Vestergaard, M. Wang, R. L. Meyer, H. Ingmer, T. B. Poulsen, T. Tørring, “Polyether Ionophore Antibiotics Target Drug-Resistant Clinical Isolates, Persister Cells, and Biofilms”, Microbiol. Spectr., 2023, 11, e00625-23, DOI: 10.1128/spectrum.00625-23
First seen on BioRxiv: doi.org/10.1101/2023.02.13.528344
60. M. Nisavic, G. J. Wørmer, C. S. Nielsen, S. M. Jeppesen, J. Palmfeldt, T. B. Poulsen, “oxSTEF Reagents Are Tunable and Versatile Electrophiles for Selective Disulfide-Rebridging of Native Proteins”, Bioconjugate Chem., 2023, 34, 994-1003, DOI: 10.1021/acs.bioconjchem.3c00005
First seen on ChemRxiv: doi.org/10.26434/chemrxiv-2022-7pkxq
59. A. Mahía, A. E. Kiib, M. Nisavic, E. B. Svenningsen, J. Palmfeldt, T. B. Poulsen, “α-Lactam Electrophiles for Covalent Chemical Biology”, Angew. Chem. Int. Ed., 2023, 62, e202304142, DOI: 10.1002/anie.202304142
First seen on ChemRxiv: doi.org/10.26434/chemrxiv-2022-p4wtd
58. E. B. Svenningsen, R. N. Ottosen, K. H. Jørgensen, M. Nisavic, C. K. Larsen, B. K. Hansen, Y. Wang, K. Lindorff-Larsen, T. Tørring, S. M. Hacker, J. Palmfeldt, T. B. Poulsen, "The Covalent Reactivity of Functionalized 5-Hydroxy-Butyrolactams Is the Basis for Targeting of Fatty Acid Binding Protein 5 (FABP5) by the Neurotrophic Agent MT-21", RSC Chem. Biol., 2022, 3, 1216-1229, DOI: 10.1039/D2CB00161F
57. F. D. Andersen, K. D. Pedersen, D. Wilkens Juhl, T. Mygind, P. Chopin, E. B. Svenningsen, T. B. Poulsen, M. Braad Lund, A. Schramm, C. H. Gotfredsen, T. Tørring, "Triculamin: An Unusual Lasso Peptide with Potent Antimycobacterial Activity", J. Nat. Prod., 2022, 85, 1514-1521, DOI: 10.1021/acs.jnatprod.2c00065
56. L. Casares, R. Moreno, K. X. Ali, M. Higgins, S. Dayalan Naidu, G. Neill, L. Cassin, A. E. Kiib, E. B. Svenningsen, A. Minassi, T. Honda, T. B. Poulsen, C. Wiel, V. I. Sayin, A. T. Dinkova-Kostova, D. Olagnier, L. de la Vega, "The Synthetic Triterpenoids CDDO-TFEA and CDDO-Me, but Not CDDO, Promote Nuclear Exclusion of BACH1 Impairing Its Activity", Redox Biol., 2022, 51, 102291, DOI: 10.1016/j.redox.2022.102291
55. G. J. Wørmer, T. B. Poulsen, "The [4.3.0] Piperidine Alkaloids: Architectures, Biology, Biosyntheses and the Complete Details of the Asymmetric Syntheses of Streptazone A and Abikoviromycin", Synlett, 2022, 33, 637-654, DOI: 10.1055/a-1688-0826
54. M. B. Cordon*, K. M. Jacobsen*, C. S. Nielsen, P. Hjerrild, T. B. Poulsen, "Forward Chemical Genetic Screen for Oxygen‐Dependent Cytotoxins Uncovers New Covalent Fragments That Target GPX4", ChemBioChem, 2022, 23, e202100253, DOI: 10.1002/cbic.202100253
*Shared first author
Featured in “Chemical Proteomics and Metabolomics” special edition. Chosen as “Very Important Paper” (VIP).
Featured as front cover
53. H. Liu, R. N. Ottosen, K. M. Jennet, E. B. Svenningsen, T. F. Kristensen, M. Biltoft, M. R. Jakobsen, T. B. Poulsen, "Macrodiolide Diversification Reveals Broad Immunosuppressive Activity That Impairs the CGAS‐STING Pathway", Angew. Chem. Int. Ed., 2021, 60, 18734–18741, DOI: 10.1002/anie.202105793
52. Y. Liu, J. A. Izzo, D. McLeod, S. Ričko, E. B. Svenningsen, T. B. Poulsen, K. A. Jørgensen, "Organocatalytic Asymmetric Multicomponent Cascade Reaction for the Synthesis of Contiguously Substituted Tetrahydronaphthols", J. Am. Chem. Soc., 2021, 143, 8208–8220, DOI: 10.1021/jacs.1c03923
49. G. J. Wørmer, N. L. Villadsen, P. Nørby, T. B. Poulsen, "Concise Asymmetric Syntheses of Streptazone A and Abikoviromycin", Angew. Chem. Int. Ed., 2021, 60, 10521–10525, DOI: 10.1002/anie.202101439
Featured as front cover
First seen on ChemRxiv: doi.org/10.26434/chemrxiv.13293356.v1
48. S. Lin, H. Liu, E. B. Svenningsen, M. Wollesen, K. M. Jacobsen, F. D. Andersen, J. Moyano-Villameriel, C. N. Pedersen, P. Nørby, T. Tørring, T. B. Poulsen, "Expanding the Antibacterial Selectivity of Polyether Ionophore Antibiotics through Diversity-Focused Semisynthesis", Nat. Chem., 2021, 13, 47–55, DOI: 10.1038/s41557-020-00601-1
First seen on ChemRxiv: doi.org/10.26434/chemrxiv.8299715.v1
47. E. B. Svenningsen, J. Thyrsted, J. Blay-Cadanet, H. Liu, S. Lin, J. Moyano-Villameriel, D. Olagnier, M. Idorn, S. R. Paludan, C. K. Holm, T. B. Poulsen, "Ionophore Antibiotic X-206 Is a Potent Inhibitor of SARS-CoV-2 Infection in Vitro", Antiviral Res., 2021, 185, 104988, DOI: 10.1016/j.antiviral.2020.104988
First seen on BioRxiv: doi.org/10.1101/2020.06.14.149153
46. D. Olagnier, E. Farahani, J. Thyrsted, J. Blay-Cadanet, A. Herengt, M. Idorn, A. Hait, B. Hernaez, A. Knudsen, M. B. Iversen, M. Schilling, S. E. Jørgensen, M. Thomsen, L. S. Reinert, M. Lappe, H.-D. Hoang, V. H. Gilchrist, A. L. Hansen, R. Ottosen, C. G. Nielsen, C. Møller, D. van der Horst, S. Peri, S. Balachandran, J. Huang, M. Jakobsen, E. B. Svenningsen, T. B. Poulsen, L. Bartsch, A. L. Thielke, Y. Luo, T. Alain, J. Rehwinkel, A. Alcamí, J. Hiscott, T. Mogensen, S. R. Paludan, C. K. Holm, "SARS-CoV2-Mediated Suppression of NRF2-Signaling Reveals Potent Antiviral and Anti-Inflammatory Activity of 4-Octyl-Itaconate and Dimethyl Fumarate", Nat. Commun., 2020, 11, 4938, DOI: 10.1038/s41467-020-18764-3
First seen on BioRxiv: doi.org/10.1101/2020.07.16.206458
45. P. Hjerrild, T. Tørring, T. B. Poulsen, "Dehydration Reactions in Polyfunctional Natural Products", Nat. Prod. Rep., 2020, 37, 1043–1064, DOI: 10.1039/D0NP00009D
Featured as front cover
44. B. K. Hansen, C. K. Larsen, J. T. Nielsen, E. B. Svenningsen, L. B. Van, K. M. Jacobsen, M. Bjerring, R. K. Flygaard, L. B. Jenner, L. N. Nejsum, D. E. Brodersen, F. A. A. Mulder, T. Tørring, T. B. Poulsen "Structure and Function of the Bacterial Protein Toxin Phenomycin", Structure, 2020, 28, 528-539.e9, DOI: 10.1016/j.str.2020.03.003
First seen on BioRxiv: doi.org/10.1101/847772
43. T. W. Golbek, L. Schmüser, M. H. Rasmussen, T. B. Poulsen, T. Weidner, "Lasalocid Acid Antibiotic at a Membrane Surface Probed by Sum Frequency Generation Spectroscopy", Langmuir, 2020, 36, 3184–3192, DOI: 10.1021/acs.langmuir.9b03752
42. F. S. Bjørnskov, T. B. Poulsen, "On the Origin of the Blind Chicken Molecule", Nat. Chem., 2020, 12, 2–3, DOI: 10.1038/s41557-019-0390-y
41. G. J. Wørmer, B. K. Hansen, J. Palmfeldt, T. B. Poulsen, "A Cyclopropene Electrophile That Targets Glutathione S‐Transferase Omega‐1 in Cells", Angew. Chem. Int. Ed., 2019, 58, 11918–11922, DOI: 10.1002/anie.201907520
40. E. B. Svenningsen, T. B. Poulsen, "Establishing Cell Painting in a Smaller Chemical Biology Lab – A Report from the Frontier", Bioorg. Med. Chem., 2019, 27, 2609–2615, DOI: 10.1016/j.bmc.2019.03.052
39. H. Liu, S. Lin, K. M. Jacobsen, T. B. Poulsen, "Chemical Syntheses and Chemical Biology of Carboxyl Polyether Ionophores: Recent Highlights", Angew. Chem. Int. Ed., 2019, 58, 13630–13642, DOI: 10.1002/anie.201812982
38. B. K. Hansen, C. J. Loveridge, S. Thyssen, G. J. Wørmer, A. D. Nielsen, J. Palmfeldt, M. Johannsen, T. B. Poulsen, "STEFs: Activated Vinylogous Protein-Reactive Electrophiles", Angew. Chem. Int. Ed., 2019, 58, 3533–3537, DOI: 10.1002/anie.201814073
37. D. Olagnier, A. M. Brandtoft, C. Gunderstofte, N. L. Villadsen, C. Krapp, A. L. Thielke, A. Laustsen, S. Peri, A. L. Hansen, L. Bonefeld, J. Thyrsted, V. Bruun, M. B. Iversen, L. Lin, V. M. Artegoitia, C. Su, L. Yang, R. Lin, S. Balachandran, Y. Luo, M. Nyegaard, B. Marrero, R. Goldbach-Mansky, M. Motwani, D. G. Ryan, K. A. Fitzgerald, L. A. O’Neill, A. K. Hollensen, C. K. Damgaard, F. v. de Paoli, H. C. Bertram, M. R. Jakobsen, T. B. Poulsen, C. K. Holm, "Nrf2 Negatively Regulates STING Indicating a Link between Antiviral Sensing and Metabolic Reprogramming", Nat. Commun., 2018, 9, 3506, DOI: 10.1038/s41467-018-05861-7
36. N. Hammer, J. D. Erickson, V. H. Lauridsen, J. B. Jakobsen, B. K. Hansen, K. M. Jacobsen, T. B. Poulsen, K. A. Jørgensen, "Catalytic Asymmetric [4+2]‐Cycloadditions Using Tropolones: Developments, Scope, Transformations, and Bioactivity", Angew. Chem. Int. Ed., 2018, 57, 13216–13220, DOI: 10.1002/anie.201808221
35. K. M. Jacobsen, N. L. Villadsen, T. Tørring, C. B. Nielsen, T. Salomón, M. M. Nielsen, M. Tsakos, C. Sibbersen, C. Scavenius, R. Nielsen, E. I. Christensen, P. F. Guerra, P. Bross, J. S. Pedersen, J. J. Enghild, M. Johannsen, J. Frøkiær, J. Overgaard, M. R. Horsman, M. Busk, T. B. Poulsen, "APD-Containing Cyclolipodepsipeptides Target Mitochondrial Function in Hypoxic Cancer Cells", Cell Chem. Biol., 2018, 25, 1337-1349.e12, DOI: 10.1016/j.chembiol.2018.07.010
34. W. Yu, P. Hjerrild, K. M. Jacobsen, H. N. Tobiesen, L. Clemmensen, T. B. Poulsen, "A Catalytic Oxidative Quinone Heterofunctionalization Method - Synthesis of Strongylophorine-26", Angew. Chem. Int. Ed.2018, 57, 9805-9809, DOI: 10.1002/anie.201805580
33. N. L. Villadsen, B. K. Hansen, E. B. Svenningsen, K. H. Jørgensen, T. Tørring, T. B. Poulsen, "Stendomycin and Pantomycin are Identical Natural Products – Preparation of a Functionalized Bioactive Analog", J. Org. Chem. 2018, 83, 7303–7308, DOI: 10.1021/acs.joc.8b00553
32. T. Salomón, C. Sibbersen, J. Hansen, D. Britz, M. V. Svart, T. S. Voss, N. Møller, N. Gregersen, K. A. Jørgensen, J. Palmfeldt, T. B. Poulsen, M. Johannsen, ”Ketone Body Acetoacetate Buffers Methylglyoxal via a Non-enzymatic Conversion during Diabetic and Dietary Ketosis”, Cell Chem. Biol. 2017, 24, 935-943, DOI: 10.1016/j.chembiol.2017.07.012
Featured on issue cover
31. E. F. Holmquist, U. B. Keiding, R. Kold-Christensen, T. Salomón, K. A. Jørgensen , P. Kristensen, T. B. Poulsen, M. Johannsen, "ReactELISA: Monitoring a Carbon Nucleophilic Metabolite by ELISA—a Study of Lipid Metabolism" Anal. Chem. 2017, 89, 5066-5071, DOI: 10.1021/acs.analchem.7b00507
30. N. L. Villadsen, K. M. Jacobsen, U. B. Keiding, E. T. Weibel, B. Christiansen, T. Vosegaard, M. Bjerring, F. Jensen, M. Johannsen, T. Tørring, T. B. Poulsen, "Synthesis of ent-BE-43547A1 reveals a potent hypoxia-selective anticancer agent and uncovers the biosynthetic origin of the APD-CLD natural products" Nat. Chem. 2017, 9, 264-272, DOI: 10.1038/nchem.2657
29. H. Feinberg, N. D. S. Rambaruth, S. A. F. Jégouzo, K. M. Jacobsen, R. Djurhuus, T. B. Poulsen, W. I. Weis, M. E. Taylor, K. Drickamer,
"Binding Sites for Acylated Trehalose Analogs of Glycolipid Ligands on an Extended Carbohydrate Recognition Domain of the Macrophage Receptor Mincle" J. Biol. Chem. 2016, 291, 21222-21333, DOI: 10.1074/jbc.M116.749515
28. M. Tsakos, K. M. Jacobsen, W. Yu, N. L. Villadsen, T. B. Poulsen,
"The Rakicidin Family of Anticancer Natural Products – Synthetic Strategies towards a New Class of Hypoxia-Selective Cytotoxins" Synlett. 2016, 27, 1898-1906, DOI: 10.1055/s-0035-1561465
27. W. Yu, P. Hjerrild, J. Overgaard, T. B. Poulsen, "A Concise Route to the Strongylophorines" Angew. Chem. Int. Ed. 2016, 55, 8294-8298, DOI: 10.1002/anie.201602476
Highlighted in Synfacts: doi.org/10.1055/s-0035-1562706
26. M. Tsakos, L. L. Clement, E. S. Schaffert, F. N. Olsen, S. Rupiani, R. Djurhuus, W. Yu, K. M. Jacobsen, N. L. Villadsen, T. B. Poulsen, "Total Synthesis and Biological Evaluation of Rakicidin A and Discovery of a Simplified Bioactive Analogue", Angew. Chem. Int. Ed. 2016, 55, 1030-1035, DOI: 10.1002/anie.201509926
Highlighted in Synfacts: doi.org/10.1055/s-0035-1561118
25. F. N. Olsen, M. Tsakos, T. B. Poulsen, "Npys-Mediated Elimination Reactions of Alcohols and Thiols: A Facile Route to Dehydroalanine and Dehydrobutyrine Building Blocks", Synlett, 2015, 26, 2697-2701, DOI: 10.1055/s-0035-1560537
24. M. Gruca, W. Yu, P. Amoateng, M. A. Nielsen, T.B. Poulsen, H. Balslev, "Ethnomedicinal survey and in vitro anti-plasmodial activity of the palm Borassus aethiopum Mart" J. Ethnopharmacol. 2015, 175, 356-369, DOI: 10.1016/j.jep.2015.09.010
23. L. L. Clement, M. Tsakos, E. S. Schaffert, C. Scavenius, J. J. Enghild, T. B. Poulsen, "The amido-pentadienoate-functionality of the rakicidins is a thiol reactive electrophile – development of a general synthetic strategy" Chem. Commun. 2015, 51, 12427-12430, DOI: 10.1039/C5CC04500B
22. M. Tsakos, E. S. Schaffert, L. L. Clement, N. L. Villadsen, T. B. Poulsen, "Ester Coupling Reactions - An Enduring Challenge in the Chemical Synthesis of Bioactive Natural Products", Nat. Prod. Rep. 2015, 32, 605-632, DOI: 10.1039/C4NP00106K
21. K. M. Jacobsen, U. B. Keiding, L. L. Clement, E. S. Schaffert, N. D. S. Rambaruth, M. Johannsen, K. Drickamer, T. B. Poulsen, "The Natural Product Brartemicin is a High Affinity Ligand for the Carbohydrate-Recognition Domain of the Macrophage Receptor Mincle", Med. Chem. Commun. 2015, 6, 647-652, DOI: 10.1039/C4MD00512K
20. T. B. Poulsen, "A Concise Route to the Macrocyclic Core of the Rakicidins", Chem. Commun. 2011, 47, 12837-12839, DOI: 10.1039/C1CC15829E
Post Doc, Harvard University, MD Shair Laboratory
19. A. W. G. Burgett, T. B. Poulsen, K. Wangkanont, D. R. Anderson, C. Kikuchi, K. Shimada, S. Okubo, K. C. Fortner, Y. Mimaki, M. Kuroda, J. P. Murphy, D. J. Schwalb, E. C. Petrella, I. Cornella-Taracido, M. Schirle, J. A. Tallarico, M. D. Shair, "Natural Products Reveal Cancer Cell Dependence on Oxysterol-Binding Proteins", Nat. Chem. Biol. 2011, 7, 639-647
Post Doc, Aarhus University, Karl Anker Jørgensen laboratory
18. G. Dickmeiss, V. De Sio, J. Udmark, T. B. Poulsen, V. Marcos, K. A. Jørgensen, "Organocatalytic Asymmetric Desymmetrization-Fragmentation of Cyclic Ketones" Angew. Chem. Int. Ed. 2009, 48, 6650-6653
17. D. G. Alberg, T. B. Poulsen, S. Bertelsen, K. L. Christensen, R. D. Birkler, M. Johannsen, K. A. Jørgensen, "Organocatalysis with Endogenous Compounds: Towards Novel Non-enzymatic Reactions" Bioorg. Med. Chem. Lett. 2009, 19, 3888-3891
PhD, Aarhus University, Karl Anker Jørgensen laboratory
16. C. B. Madsen, L. B. Madsen, S. S. Viftrup, M. P. Johansson, T. B. Poulsen, L. Holmegaard, V. Kumarappan, K. A. Jørgensen, H. Stapelfeldt, "A Combined Experimental and Theoretical Study on Realizing and Using Laser Controlled Torsion of Molecules" J. Chem. Phys. 2009, 130, 234310
15. C. B. Madsen, L. B. Madsen, S. S. Viftrup, M. P. Johansson, T. B. Poulsen, L. Holmegaard, V. Kumarappan, K. A. Jørgensen, H. Stapelfeldt, "Manipulating the Torsion of Molecules by Strong Laser Pulses" Phys. Rev. Lett. 2009, 102, 073007
14. T. B. Poulsen, G. Dickmeiss, J. Overgaard, K. A. Jørgensen, "Organocatalytic Asymmetric Synthesis of Versatile gamma-Lactams" Angew. Chem. Int. Ed. 2008, 47, 4687-4690
13. T. B. Poulsen, K. A. Jørgensen, "Catalytic Asymmetric Friedel-Crafts Alkylation Reactions – Copper Showed the Way" Chem. Rev. 2008, 108, 2903-2915
12. S. Santoro, T. B. Poulsen, K. A. Jørgensen, "Enantioselective Organocatalytic Substitution of αlfa-Cyanoacetates on Imidoyl Chlorides – Synthesis of Optically Active Ketimines" Chem. Commun. 2007, 5155-5157
11. J. López-Cantarero, M. Belén Cid, T. B. Poulsen, M. Bella, J. L. G. Ruano, K. A. Jørgensen, "Intriguing Behaviour of Cinchona Alkaloids in the Enantioselective Organocatalytic Hydroxyamination of alfa-Substututed-alfa-Cyanoacetates" J. Org. Chem. 2007, 72, 7062-7065
10. M. Bell, T. B. Poulsen, K. A. Jørgensen, "Organocatalytic Enantioselective Nucleophilic Vinylic Substitution by alfa-Substituted-alfa-Cyanoacetates under Phase-Transfer Conditions" J. Org. Chem. 2007, 72, 3053-3056
9. T. B. Poulsen, L. Bernardi, J. Alemán, J. Overgaard, K. A. Jørgensen, "Organocatalytic Asymmetric alfa-Alkynylation of Cyclic beta-Ketoesters" J. Am. Chem. Soc. 2007, 129, 441-449
8. T. B. Poulsen, L. Bernardi, M. Bell, K. A. Jørgensen, "Organocatalytic Enantioselective Nucleophilic Vinylic Substitution" Angew. Chem. Int. Ed. 2006, 45, 6551-6554
7. T. B. Poulsen, M. Bell, K. A. Jørgensen, "Organocatalytic Asymmetric Allylic Carbon-Carbon Bond Formation" Org. Biomol. Chem. 2006, 4, 63-70 (Selected for Issue Cover)
6. T. B. Poulsen, C. Alemparte, K. A. Jørgensen, "Enantioselective Organocatalytic Allylic Amination" J. Am. Chem. Soc. 2005, 127i, 11614-11615
5. W. Zhuang, T. B. Poulsen, K. A. Jørgensen, "A versatile catalyst for asymmetric reactions of carbonyl groups working purely by activation through hydrogen bonding: Mukaiyama-aldol, hetero Diels-Alder and Friedel-Crafts reactions" Org. Biomol. Chem. 2005, 3, 3284-3289
4. M. Marigo, J. Franzén, T. B. Poulsen, W. Zhuang, K. A. Jørgensen, "Asymmetric Organocatalytic Epoxidation of alfa,beta-Unsaturated Aldehydes with Hydrogen Peroxide" J. Am. Chem. Soc. 2005, 127, 6964-6965
3. T. B. Poulsen, C. Alemparte, S. Saaby, M. Bella, K. A. Jørgensen, "Direct Organocatalytic and Highly Enantio- and Diastereoselective Mannich Reactions of alfa-Substituted-alfa-Cyanoacetates" Angew. Chem. Int. Ed. 2005, 44, 2896-2899
Undergraduate, Aarhus University, Karl Anker Jørgensen laboratory
2. N. Gathergood, K. Juhl, T. B. Poulsen, K. Thordrup, K. A. Jørgensen, "Direct catalytic asymmetric aldol reactions of pyruvates: scope and mechanism" Org. Biomol. Chem. 2004, 2, 1077-1085
1. A. Bøgevig, T. B. Poulsen, W. Zhuang, K. A. Jørgensen, "Formation of Optically Active Functionalized beta-Hydroxy Nitrones Using a Proline Catalyzed Aldol Reaction of Aldehydes with Carbonyl Compounds and Nydroxylamines”, Synlett, 2003, 12, 1915-1918

![Read the 'behind the scenes' of Gustav's work on the [4.3.0] Piperidine Alkaloids in Synlett](https://images.squarespace-cdn.com/content/v1/5b3ddeada2772cc5c397a174/1636559486385-U0DK30PMD3GQBVYXHF8E/image-asset.png)
















![36. N. Hammer, J. D. Erickson, V. H. Lauridsen, J. B. Jakobsen, B. K. Hansen, K. M. Jacobsen, T. B. Poulsen, K. A. Jørgensen, "Catalytic Asymmetric [4+2]‐Cycloadditions Using Tropolones: Developments, Scope, Transformations, and Bioactivity", Angew](https://images.squarespace-cdn.com/content/v1/5b3ddeada2772cc5c397a174/1585396955019-KS28XYJLR41E2L5JM9TW/Angew1.png)















